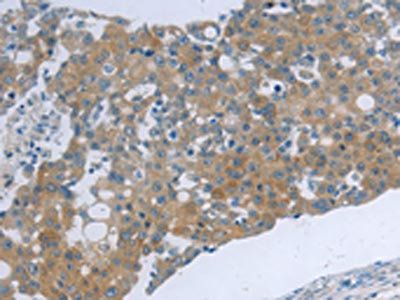
TNK2 Antibody

You have no items in your shopping cart.
Search results for: 'CDC42'
- ACK1 (Phospho-Y284) Antibody [orb304637]
IF, IHC, WB
Bovine, Human, Mouse, Porcine, Rat
Rabbit
Polyclonal
Unconjugated
100 μl, 200 μl, 30 μl, 50 μl - CDC42 Antibody [orb1728175]
ELISA, FC, ICC, IF, WB
Human, Mouse, Rat
Rabbit
Polyclonal
Unconjugated
100 μg - CDC42EP3 Antibody (N-term) [orb39468]Featured

FC, IHC-P, WB
Human
Mouse
Rabbit
Polyclonal
Unconjugated
80 μl